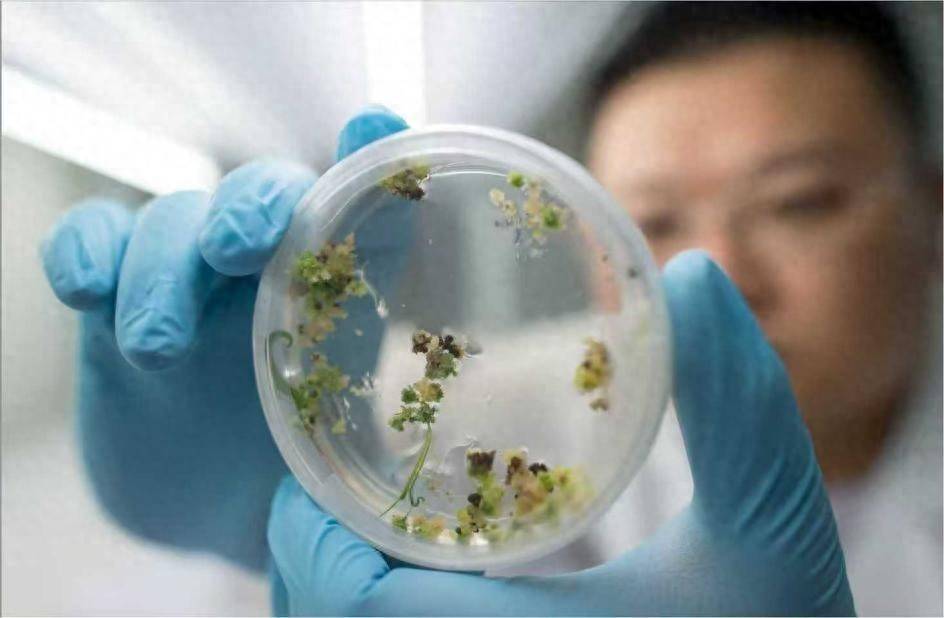

(人民日报健康客户端记者 王卓)“过去在很多医药领域,我们的创新动力不足、产业相对薄弱,行业强调要加强创新,提升科技能力深富优配,但这是远远不够的。”中国科学院上海药物研究所研究员陈凯先表示,生物医药产业需要构成良好的创新“生态圈”。
在国家高新技术“863”计划、国家新药创制重大专项等项目的支持下,今年7月份,重组人白蛋白注射液(水稻)通过国家药监局优先审评审批程序获批上市,适用于肝硬化低白蛋白血症(≤30克/升)的治疗。政策导向加资本支持,科研人员和创新企业的研发勇气得到激励,越来越多的原研新药正在加速产业化并临床应用。
研究人员在研发实验室。受访者供图
突破新技术,缓解人血清白蛋白临床应用紧张情况广西医科大学第一附属医院主任医师赖永榕介绍,人血清白蛋白在肿瘤患者术后、救治危急重症等临床领域都有广泛应用,在肝硬化及其并发症、休克与低血容量复苏、新生儿高胆红素血症等疾病治疗方面具有重要临床价值。
“然而深富优配,国内人血清白蛋白治疗药物在临床上的使用长期依赖国外进口,仍存在较大供需缺口,要在各个部门联防联控的管制下进行临床应用。”首都医科大学肺癌诊疗中心主任支修益坦言。
20世纪80年代基因工程技术出现以后,很多国内外科学家开展了科研攻关,希望运用重组技术把白蛋白在实验室、生产线上做出来,但很遗憾一直没成功。武汉大学生命科学学院教授杨代常解决了重组人血清白蛋白的纯度、规模化和成本等很多技术问题。“这项技术是利用水稻胚乳细胞表达,经提取、纯化的重组人血清白蛋白。”全国政协委员、国家“重大新药创制”专项总体组专家丁列明博士对人民日报健康客户端表示。
“更重要的是,这项技术开辟了利用植物的细胞来表达人体蛋白,再生产药物的技术平台。”陈凯先认为,未来可以推广到许多其他类型药物的研发,运用植物细胞表达来解决保障药品供应稳定的问题。
创新转化离不了资金支持,国家导向和产业资本缺一不可2012年,国家“重大新药创制”专项总体组到武汉禾元生物,考察了重组人白蛋白技术的研发。“当时,这项技术已经进入临床试验阶段。由于是从植物源转化为人用的产品,完全打破了常规思维,不仅技术难度非常大,在研发过程中还长期面临着融资难题。”丁列明回忆道。
陈凯先谈到,在研发的早期阶段,市场还不能充分发挥作用,国家层面的投入显得更为重要,因此也会更偏重于基础科研。而研究进入到稳定进展的阶段时,市场资本就会积极投入。国家投入和市场投入是相互协同的过程深富优配,二者缺一不可。
在国家“重大新药创制”专项支持的基础上,贝达产业创新基金又投入了5亿元。“不仅在资金上,更重要的是我们还要利用企业药物创新的经验和优势,来帮助他们完成后面的临床研究和产业化,直到目前药品上市后,继续开展商业推广的合作。”丁列明提到。
“产业背景的团队与高校研究人员联合,用资本为科研赋能,让医药企业创新形成合力非常重要。”丁列明解读道,国家级项目的支持资金可能是有限的,不过起到的是引领作用,能够吸引更多民营资本的基金和投资进入到医药产业。
“政产学研医资”协同,构建良好的创新“生态圈”“我国医药产业在不同的发展阶段也在不断产生新问题、新矛盾,需要不断改革和完善。”陈凯先表示,当前,国家将政策引导、人才聚集、资本支持和公共平台等多方面汇集,构成“政产学研医”的协同创新“生态圈”,得以让科研的“奇思妙想”转化为现实的产业成果。
国家药监局9月1日公布数据显示,“十四五”期间,国家药监局共批准创新药210个、创新医疗器械269个,且均保持加速增长态势。目前,我国生物医药市场规模跃居全球第二,在研创新药约占全球的30%份额。
近年来,我国药品审评审批制度改革持续深化,创新药审评用时大幅缩短。重组人白蛋白注射液通过优先审评审批程序,比常规审批提前近70个工作日获得通过。
支修益教授还谈道,中国生物医药已经迈入创新药时代,医药创新“生态圈”的形成,让科研人员更有勇气去探索和冒险,领域内的创新活力持续迸发。我国还实现了从新药引进到原研出海的逆转。当前全球医药领域每10个技术交易项目中,就有3个以上来自中国,中国创新药的出海势头正愈发强劲。
据介绍深富优配,武汉禾元生物已建成符合国际标准的智能化生产线,可年产1200万瓶重组人白蛋白注射液,该药品也已经在美国获得批准开展Ⅲ期临床研究。
御龙优配提示:文章来自网络,不代表本站观点。